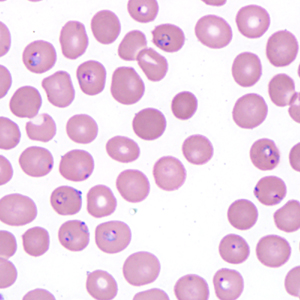
Case403_C.jpg

Case #403 – September 2015
A 25-year-old male presented to the ER with complaints of dizziness, headache, ear pain, fever, chills, and malaise approximately one week after returning from a missionary trip to Ghana. The patient claims to have been compliant with anti-malarial prophylaxis. A blood specimen was collected in EDTA and sent to the Hematology lab for processing. While admitted at the hospital, he developed thrombocytopenia, reticulocytosis, and hyperbilirubinemia. Figures A and B show what was observed on a thick blood film stained with Wright stain; figures C and D show what was observed on a thin blood film stained with Wright stain. What is your diagnosis? Based on what criteria?

Figure A

Figure B
Figure C

Figure D
Images presented in the DPDx case studies are from specimens submitted for diagnosis or archiving. On rare occasions, clinical histories given may be partly fictitious.
DPDx is an educational resource designed for health professionals and laboratory scientists. For an overview including prevention, control, and treatment visit www.cdc.gov/parasites/.